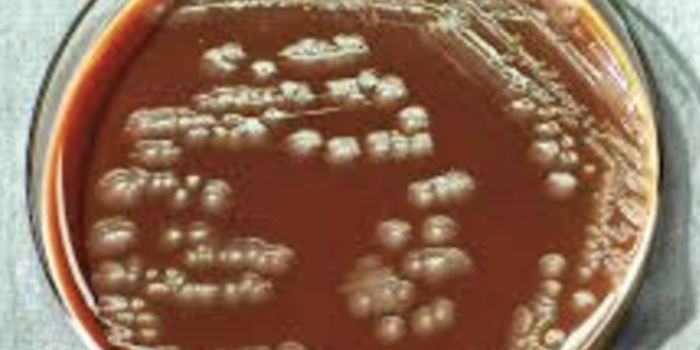
Finding Sleeper Cells That Evade Drug Treatment

Animal infection
Animal infections occur when an agent invades a host animal's tissues where it replicates and releases toxins causing disease. Some animal infections, known as zoonotic diseases, can be transferred to humans.
-
JAN 24, 2018CardiologyWhen babies are born too early, they run the risk of developing problems in the lungs, brain, kidneys and more. Now, fro ...Written By: Kara MarkerJAN 24, 2018Chemistry & PhysicsThe word "elixir" comes from Greek origin of "powder for drying wounds". Its modern definition means ...Written By: Daniel DuanJAN 17, 2018Plants & AnimalsBack in 2015, a population of roughly 200,000 saiga antelopes (Saiga tatarica) dropped dead in Kazakhstan for seemingly ...Written By: Anthony BouchardJAN 16, 2018CardiologyA new treatment to be used in the wake of a heart attack is a little bit like putting a bandaid on a cut to prevent it f ...Written By: Kara MarkerJAN 04, 2018ImmunologyHow does a West African monkey species called sooty mangabeys resist SIV, the “monkey version” of HIV, and p ...Written By: Kara MarkerJAN 03, 2018MicrobiologyEbola has caused serious outbreaks in recent years; the last one that struck West Africa was a virulent strain that kill ...Written By: Carmen LeitchDEC 29, 2017Genetics & GenomicsSome of the worst wildlife diseases have been fungal. Now scientists have found that a fungus is impacting snakes.Written By: Carmen LeitchDEC 26, 2017MicrobiologyOne way that bacterial infections get around antibiotics is by using sleeper cells; these special cells lie dormant, sur ...Written By: Carmen LeitchDEC 26, 2017CancerThese families give rave reviews of Animal Assisted Interaction in hospitals.Written By: Julia TraversDEC 19, 2017Drug Discovery & DevelopmentResearchers develop new "universal" antibody to target seasonal influenza to lay the foundation for future vaccine devel ...Written By: Courtney SchaalDEC 13, 2017VideosResearchers from the Texas Biomedical Research Institute have found a new, possibly more ideal animal model of a Zika vi ...Written By: Kara MarkerDEC 01, 2017MicrobiologyRabies is a fatal viral disease that occurs in more than 150 countries and territories, causing more than 60,000 fatalit ...Written By: Sarah HertrichNOV 30, 2017Health & MedicineLyme disease is on the rise in the United States, but not in the areas where it is most commonly found. Lyme disease can ...Written By: Brenda Kelley KimNOV 30, 2017MicrobiologyBrachyspira pilosicoli is a slow growing spirochete that was first isolated from a pig in the United Kingdom in 1980. Sp ...Written By: Sarah HertrichNOV 22, 2017MicrobiologyA prion is an infectious agent responsible for several neurodegenerative diseases including Creutzfeldt-Jakob disease (C ...Written By: Sarah HertrichNOV 22, 2017MicrobiologySalmonella enterica is the leading cause of bacterial illness in the United States as well as other parts of the world. ...Written By: Sarah HertrichNOV 22, 2017Clinical & Molecular DXThe controversial Italian surgeon on the impossible quest to transplant a human head recently claimed to have “suc ...NOV 16, 2017Plants & AnimalsWhile dentists may perform their fair share of root canal procedures on human patients, you’d be hard-pressed to f ...Written By: Anthony BouchardNOV 16, 2017MicrobiologyMounting evidence reported by scientists all over the world suggests that infections caused by microorganisms such as ba ...Written By: Sarah HertrichNOV 12, 2017Drug Discovery & DevelopmentBacteria has continued to evolve, becoming resistant to antibiotics, but scientists have found a screen to help combat t ...Written By: Courtney SchaalNOV 11, 2017MicrobiologyMethicillin-resistant Staphylococcus aureus, also known as MRSA, is a type of antibiotic resistant bacteria that causes ...Written By: Sarah HertrichNOV 10, 2017MicrobiologyChronic wasting disease (CWD) is a contagious neurological disorder that affects deer, elk, reindeer, and moose that lea ...Written By: Sarah HertrichNOV 08, 2017MicrobiologyOver the last several decades the growth of the aquaculture industry has accelerated. Aquaculture can be defined as the ...Written By: Sarah HertrichNOV 06, 2017MicrobiologyToxoplasma gondii is a single-celled parasite that causes toxoplasmosis. The parasite can be found throughout the world ...Written By: Sarah Hertrich
JAN 24, 2018
Cardiology
When babies are born too early, they run the risk of developing problems in the lungs, brain, kidneys and more. Now, fro
...
Written By:
Kara Marker
JAN 24, 2018
Chemistry & Physics
The word "elixir" comes from Greek origin of "powder for drying wounds". Its modern definition means
...
Written By:
Daniel Duan
JAN 17, 2018
Plants & Animals
Back in 2015, a population of roughly 200,000 saiga antelopes (Saiga tatarica) dropped dead in Kazakhstan for seemingly
...
Written By:
Anthony Bouchard
JAN 16, 2018
Cardiology
A new treatment to be used in the wake of a heart attack is a little bit like putting a bandaid on a cut to prevent it f
...
Written By:
Kara Marker
JAN 04, 2018
Immunology
How does a West African monkey species called sooty mangabeys resist SIV, the “monkey version” of HIV, and p
...
Written By:
Kara Marker
JAN 03, 2018
Microbiology
Ebola has caused serious outbreaks in recent years; the last one that struck West Africa was a virulent strain that kill
...
Written By:
Carmen Leitch
DEC 29, 2017
Genetics & Genomics
Some of the worst wildlife diseases have been fungal. Now scientists have found that a fungus is impacting snakes.
Written By:
Carmen Leitch
DEC 26, 2017
Microbiology
One way that bacterial infections get around antibiotics is by using sleeper cells; these special cells lie dormant, sur
...
Written By:
Carmen Leitch
DEC 26, 2017
Cancer
These families give rave reviews of Animal Assisted Interaction in hospitals.
Written By:
Julia Travers
DEC 19, 2017
Drug Discovery & Development
Researchers develop new "universal" antibody to target seasonal influenza to lay the foundation for future vaccine devel
...
Written By:
Courtney Schaal
DEC 13, 2017
Videos
Researchers from the Texas Biomedical Research Institute have found a new, possibly more ideal animal model of a Zika vi
...
Written By:
Kara Marker
DEC 01, 2017
Microbiology
Rabies is a fatal viral disease that occurs in more than 150 countries and territories, causing more than 60,000 fatalit
...
Written By:
Sarah Hertrich
NOV 30, 2017
Health & Medicine
Lyme disease is on the rise in the United States, but not in the areas where it is most commonly found. Lyme disease can
...
Written By:
Brenda Kelley Kim
NOV 30, 2017
Microbiology
Brachyspira pilosicoli is a slow growing spirochete that was first isolated from a pig in the United Kingdom in 1980. Sp
...
Written By:
Sarah Hertrich
NOV 22, 2017
Microbiology
A prion is an infectious agent responsible for several neurodegenerative diseases including Creutzfeldt-Jakob disease (C
...
Written By:
Sarah Hertrich
NOV 22, 2017
Microbiology
Salmonella enterica is the leading cause of bacterial illness in the United States as well as other parts of the world.
...
Written By:
Sarah Hertrich
NOV 22, 2017
Clinical & Molecular DX
The controversial Italian surgeon on the impossible quest to transplant a human head recently claimed to have “suc
...
NOV 16, 2017
Plants & Animals
While dentists may perform their fair share of root canal procedures on human patients, you’d be hard-pressed to f
...
Written By:
Anthony Bouchard
NOV 16, 2017
Microbiology
Mounting evidence reported by scientists all over the world suggests that infections caused by microorganisms such as ba
...
Written By:
Sarah Hertrich
NOV 12, 2017
Drug Discovery & Development
Bacteria has continued to evolve, becoming resistant to antibiotics, but scientists have found a screen to help combat t
...
Written By:
Courtney Schaal
NOV 11, 2017
Microbiology
Methicillin-resistant Staphylococcus aureus, also known as MRSA, is a type of antibiotic resistant bacteria that causes
...
Written By:
Sarah Hertrich
NOV 10, 2017
Microbiology
Chronic wasting disease (CWD) is a contagious neurological disorder that affects deer, elk, reindeer, and moose that lea
...
Written By:
Sarah Hertrich
NOV 08, 2017
Microbiology
Over the last several decades the growth of the aquaculture industry has accelerated. Aquaculture can be defined as the
...
Written By:
Sarah Hertrich
NOV 06, 2017
Microbiology
Toxoplasma gondii is a single-celled parasite that causes toxoplasmosis. The parasite can be found throughout the world
...
Written By:
Sarah Hertrich